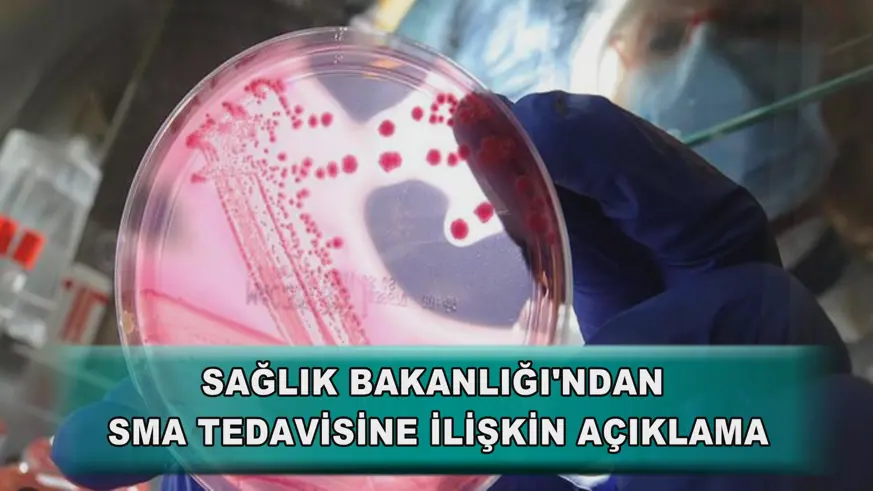
Sağlık Bakanlığı'ndan SMA tedavisine ilişkin açıklama

Sağlık Bakanlığı, SMA Bilim Kurulunun hastalığa yönelik tıbbi gelişmeleri titizlikle takip ettiğini ve tedavi süreçlerinde bilimsel verileri esas aldığını bildirdi.
Bakanlığın sosyal medya hesabından yapılan açıklamada, SMA hastalığında dünyada kullanılan Nusinersen ve Risdiplam etken maddeli iki ilacın, Türkiye'de erişime açık olduğu belirtilerek, 2017'de Yurt Dışı İlaç Listesi'ne eklenen Nusinersen'in 2022'de ruhsatlandırılıp geri ödeme kapsamına alındığı, Risdiplam'ın ise 2020'de listeye eklenip 2024'te ruhsatlandırıldığı ifade edildi.
"Zolgensma isimli ilaç, SMA Bilim Kurulu tarafından mevcut tedaviden üstün olduğuna dair bir kanıt bulunmadığından Yurt Dışı İlaç Listesi'ne dahil edilmemiştir." değerlendirmesine yer verilen açıklamada, SMA Bilim Kurulunun, hastalığa yönelik tıbbi gelişmeleri titizlikle takip ettiği ve tedavi süreçlerinde bilimsel verileri esas aldığı bildirildi.
Uluslararası çok merkezli yüksek kaliteli klinik araştırmalardan gelecek uzun dönem verilerinin, SMA konusundaki kararların dayanağı olacağı vurgulanan açıklamada, şunlar kaydedildi:
"SMA konusundaki takiplerimiz, uygulamaya konulan tedavilerin hastalara sağladığı fayda ile tedavinin maliyetini rasyonalize etmeyi de içermektedir. Sağlık Bakanlığı ve ilgili kurullar, yeni seçenekleri değerlendirirken, Türkiye'nin toplam ilaç harcama bütçesini ve diğer hastalıkların tedavisini de dikkate almak zorundadır. Türkiye, vatandaşlarına finanse ederek sunduğu ilaç ve tıbbi cihaz hizmeti konusunda dünyanın en önemli sosyal devletlerinden biridir."
Kaynak: Anadolu Ajansı